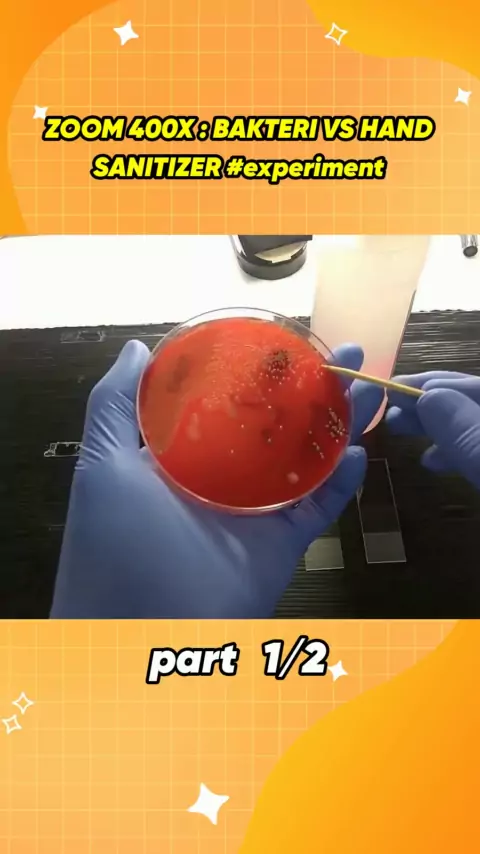
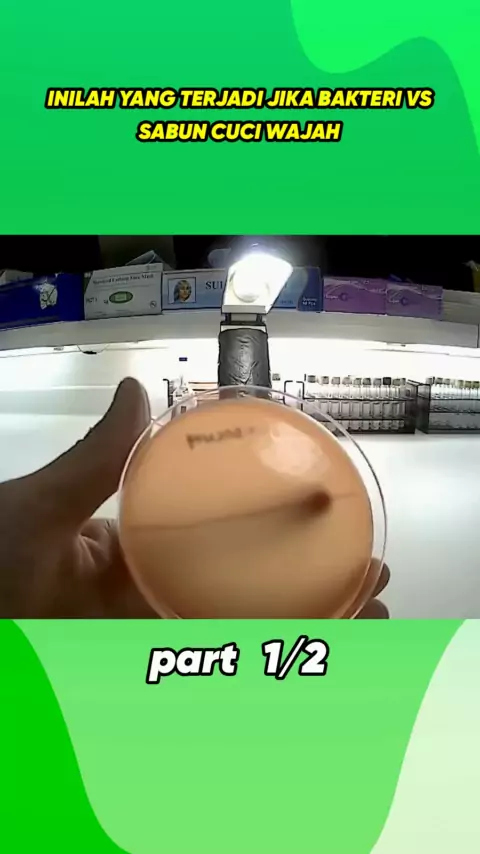
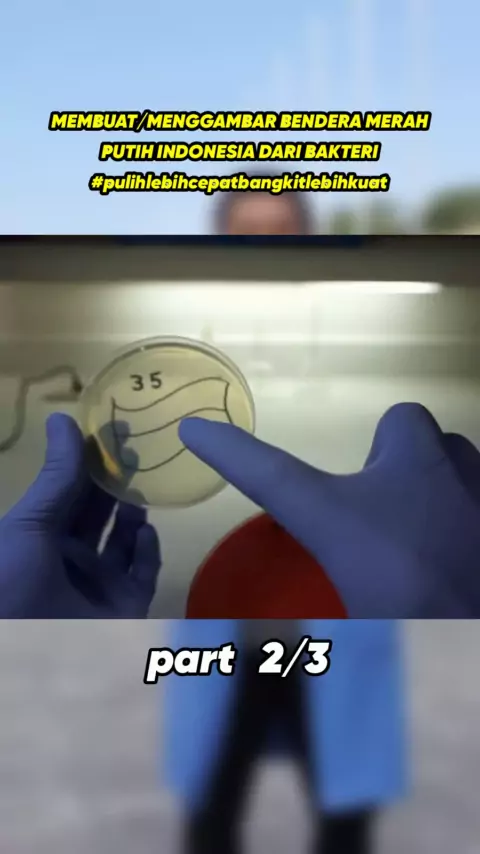
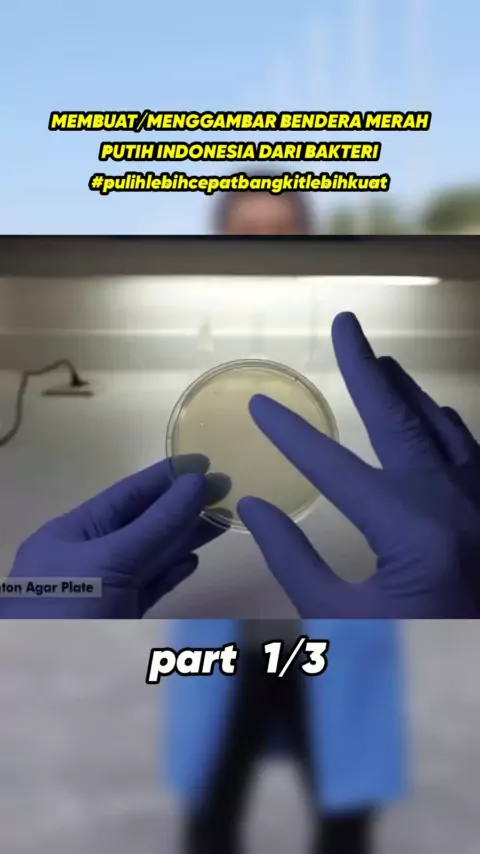

daribex

110
Posts

All playlists · Total 50

2
ZOOM 1000X : AIR BAKU VS AIR MATANG #eksperimen

4
DARI MULAI DI COLOK SAMPE DIPERIKSA DI ALAT, SEPERTI INILAH PROSESNYA ...

3
ZOOM 1000X : BAKTERI DI UDARA #experiment #bakteri

3
MEMBUAT/MENGGAMBAR BENDERA MERAH PUTIH INDONESIA DARI BAKTERI #pulihlebihcepatbangkitlebihkuat

2
Cara Cuci Tangan Yang Benar #bakteri #virus

2
Benda tajam? Buang aja di Sharp Collector #sharpcollector

3
Experiment : BAKTERI DALAM SUSU yang disimpan selama 12 jam #experiment #bakteri #susu

4
Membuat Preparat BTA yang Baik #preparat #bta #tuberculosis

3
ZOOM 1000X: HIDUP PADA AIR LIMBAH PERALATAN CUCI LIMBAH DAN SIKAT GIGI BEKAS #experiment #bacteria

4
ZOOM 1000X : KUTU LONCAT PADA KUCING, Ctenocephalides felis Under Microscope #microscope #zoom1000x

3
EXPERIMENT MENDETEKSI BORAKS DALAM BAKSO | AWAS BAKSO BERBAHAYA !!!
2
ZOOM 400X : BAKTERI VS HAND SANITIZER #experiment

3
ZOOM 1000X : JAMUR ENOKI | ENAK SIH TAPI ...

3
OLI BEKAS VS OLI BARU JIKA DILIHAT DENGAN MIKROSKOP ~ ( CAR OIL UNDER MICROSCOPE )

3
ZOOM 1000X SALIVA THUG #percobaan

2
ZOOM 1000X : BAKTERI PADA YAKULT & YOGURT #experiment

2
INILAH YANG TERJADI JIKA BAKTERI VS SABUN CUCI WAJAH

2
ZOOM 1000X : DARAH MANUSIA
2
INILAH YANG TERJADI JIKA BAKTERI VS SABUN CUCI WAJAH

2
ZOOM 1000X : DARAH MANUSIA